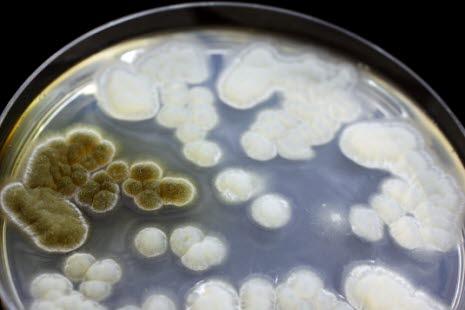
Mikroorganismer

Kryptokokkose
Kryptokokkose er en infeksjon forårsaket av soppen Cryptococcus neoformans som oppstår nesten utelukkende hos immunsvekkede og i 80-90 prosent av tilfellene hos personer med aids.
Sist oppdatert:
12. feb. 2021
Hva er kryptokokkose?
Det er en infeksjon forårsaket av Cryptococcus neoformans, en gjærsopp. Infeksjonen oppstår nesten utelukkende hos immunsvekkede og 80-90 prosent av tilfellene oppstår hos personer med aids. Av de resterende tilfellene oppstår om lag halvparten hos immunfriske, mens kreftsykdom, særlig Hodgkins sykdom og non-Hodgkins sykdom, og organtransplantasjon er viktige risikofaktorer i den siste gruppen.
Infeksjonen oppstår først i lungene og er oftest uten symptomer. Utbredt sykdom viser seg oftest som hjernehinnebetennelse (kryptokokkmeningitt).
Forekomsten av kryptokokkose har økt i takt med økningen i forekomsten av hiv og aids. Likevel er det en meget sjelden sykdom. Vi regner med det oppstår 1-2 nye tilfeller per år i Norge.
Årsaker
De viktigste disponerende faktorene for kryptokokksykdom er hiv-infeksjon, steroidbehandling, organtransplantasjon, kronisk leukemi, lymfom og sarkoidose. Hos disse pasientgruppene er immunforsvaret svekket. Soppen (kryptokokkene) som menneskekroppen vanligvis ikke har noe problem å kvitte seg med, blir værende og kan forårsake en infeksjon.
Inngangsporten er via luftveiene og lungene. Dersom det utvikler seg infeksjon, sprer soppen seg med blodet, blant annet til hjernen.
Diagnostikk
Utbredt sykdom kan involvere hvilket som helst organ, men sykdom i sentralnervesystemet dominerer. Symptomene er gjerne milde og uspesifikke og har ikke sjelden et forløp der symptomene kommer og går. Hodepine, slapphet, feber er ganske vanlig. Forvirring og andre mentale forandringer så vel som hjernenerveutfall, kvalme og brekninger kan observeres etter som sykdommen øker på.
Dyrkningsprøver fra blodet kan gi oppvekst av sopp, men det tar mange dager før svaret foreligger. Immunologiske metoder med påvisning av såkalt antigen, gir en rask diagnose. Ved hjernehinnebetennelse tas det prøver fra spinalvæsken.
Behandling
Ubehandlet er kryptokokkmeningitt en sykdom med 100 prosent dødelighet. Tidlig diagnostikk og behandling kan være avgjørende for utfallet.
Behandlingen innebærer bruk av soppdrepende midler. Først gis medisinen direkte i blodet (intravenøst), senere fortsetter gjerne behandlingen med tabletter i opptil 6-8 uker. Intensiteten i behandlingen avgjøres av sykdommens alvorlighetsgrad.
Prognose
Utfallet avhenger mye av den tilgrunnliggende sykdommen. Kryptokokkose kan være en sykdom som oppstår i sluttfasen av en aids- eller kreftsykdom. Men dersom pasienten ikke er alvorlig syk, er utsiktene gode for å bli kvitt denne soppinfeksjonen.
Vil du vite mer
Dette dokumentet er basert på det profesjonelle dokumentet Kryptokokkose . Referanselisten for dette dokumentet vises nedenfor
- Sivertsen EA, Torfoss D. Kryptokokkmeningitt. Tidsskr Nor Lægeforen 2004; 124: 28-30. PubMed
- King JW. Cryptococcosis. Medscape, last updated Jul 06, 2017. emedicine.medscape.com
- Folkehelseinstituttet. Kryptokokkose - veileder for helsepersonell. Smittevernveilederen, sist oppdatert 19.04.2019. fhi.no
- Velagapudi R, Hsueh YP, Geunes-Boyer S, et al. Spores as infectious propagules of Cryptococcus neoformans. Infect Immun 2009; 77:4345. PubMed
- Chayakulkeeree M, Perfect JR. Cryptococcosis. Infect Dis Clin North Am. 2006;20:507-544. PubMed
- Haug JB (red). Nasjonal Faglig retningslinje for bruk av antibiotika i sykehus. Systemiske soppinfeksjoner. Helsedirektoratet 2013. helsedirektoratet.no
- Perfect JR, Dismukes WE, Dromer F, et al. Clinical practice guidelines for the management of cryptococcal disease: 2010 update by the infectious diseases society of america. Clin Infect Dis 2010; 50: 291-322. PubMed
- Thompson GR III, Rendon A, dos Dantos RR, et alIsavuconazole treatment of cryptococcosis and dimorphic mycoses. Clin Infect Dis 2016; 63:356. doi: 10.1093/cid/ciw305 DOI